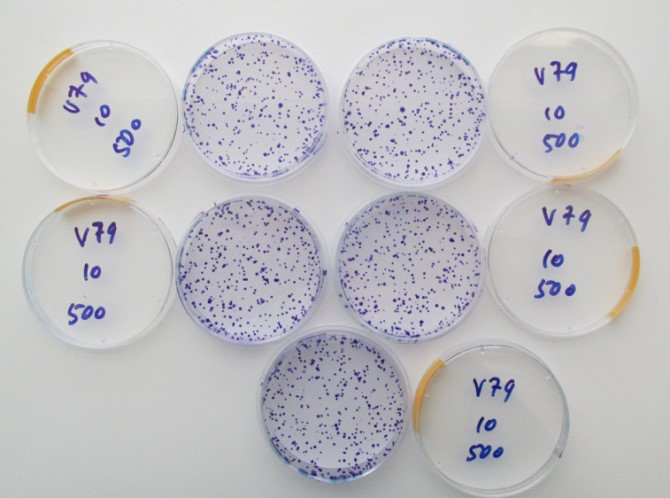

В Институте ядерной физики им. Г. И. Будкера СО РАН уже создан новый тип источника эпитепловых нейтронов на основе ускорителя-тандема с вакуумной изоляцией и литиевой мишенью, на котором впервые в мире получен пучок нейтронов с потоком, достаточным для БНЗТ. В нем реализованы новые защищенные патентами идеи, обеспечивающие наилучшее качество пучка нейтронов. На базе Новосибирского государственного университета, в лаборатории, занимающейся физическими проблемами БНЗТ, продолжаются работы по модернизации ускорительного источника и предлагаются новые конструкторские решения для обеспечения оптимальных и стабильных параметров терапевтического пучка.
На конференции, которая состоялась в Новосибирске, был представлен доклад «Технология бор-нейтронозахватной терапии (БНЗТ) для лечения онкологических больных. Первые результаты». В роли докладчика выступил заведующий лабораторией БНЗТ Физического факультета НГУ, доктор физико-математических наук, доцент Сергей Таскаев.
— В результате поглощения нейтрона бором происходит ядерная реакция с большим выделением энергии в клетке, что приводит к гибели последней. Проведенные клинические испытания на ядерных реакторах показали, что БНЗТ позволяет лечить глиобластомы мозга, метастазы меланомы и еще ряд других злокачественных опухолей. На нашем источнике нам удалось пока вылечить только мышей с привитой глиобластомой человека, что оказалось реально сложнее, чем вылечить человека, поскольку приходилось облучать мышь всю, а бор накопился не только в опухоли, — рассказал Сергей Таскаев. Таким образом, подтверждена эффективность БНЗТ при различных типах злокачественных опухолей человека. Это касается прежде всего опухолей головного мозга (глиобластома), рака молочной железы, меланомы, аденокарциномы толстой кишки. Ключевым моментом является потенциальная возможность лечить с помощью источника нейронов те виды рака, которые устойчивы к другим видам облучения и химиотерапии, а также метастазы.
— Одной из проблем БНЗТ является адресная доставка бора в клетки опухоли. Дело в том, что, если бор-10 проникнет в здоровые ткани организма, облучение нейтронами нанесет им вред. Поэтому важно не только насытить опухоль препаратом, но и не дать бору распространиться по телу, чтобы дозу облучения не получил весь организм. Сейчас мировые исследования сосредоточены на наночастицах, способных доставлять препараты непосредственно в раковую клетку. В лаборатории медико-биологических проблем БНЗТ в качестве агента направленной доставки бора-10 в опухоль используются липосомы. В исследованиях изучены механизмы проникновения липосом в опухолевые и нормальные клетки человека, показаны преимущества использования липосом в качестве носителей бора для БНЗТ. Использование новых методов доставки бора-10 позволяет увеличить его концентрацию в опухоли в десятки раз по сравнению с существующими средствами, что, в свою очередь, позволит снизить необходимую дозу облучения и сохранить здоровые ткани организма, — отметил заведующий лабораторией медико-биологических проблем БНЗТ ФФ НГУ Владимир Каныгин.
Источник: пресс-служба НГУ
Коллектив ученых, занимающихся работами по БНЗТ, недавно выиграл грант РНФ на 4 года с возможностью продления в случае успеха. Цель проекта — подготовить к 2022 году ускорительный источник нейронов к терапии и в случае получения разрешения провести БНЗТ на этой установке. На создание аппарата ушло 20 лет. Конечным этапом данной работы будет лечение людей, и это случится совсем скоро.